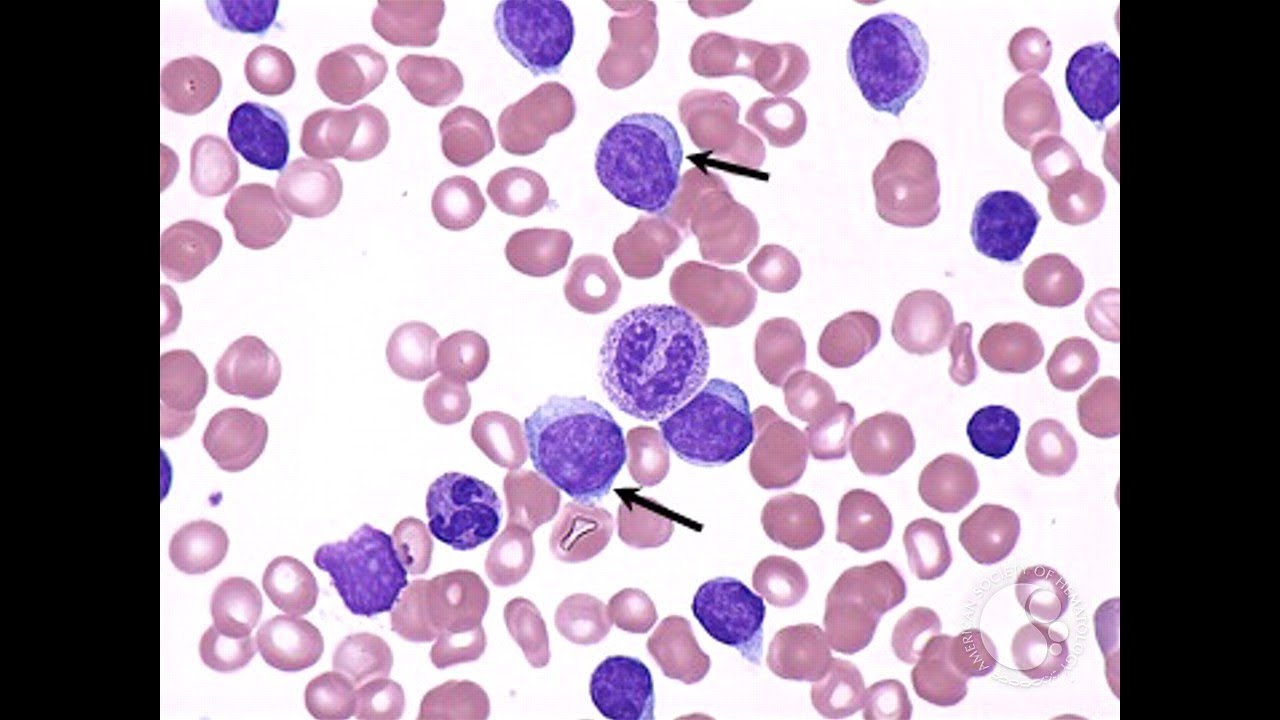

Хронический лимфолейкоз б
Хронический лимфолейкоз б 110 фото
Дикий рис как готовить
И пускай наша песенка спета
Худые путаны
Отжимания за 15 недель
Помогает против морщин
Обязательно ли регистрироваться на рейс
Фамилия крылатых
Свекровь дерется
Анимировать арт
Раскраски мир машин
Крупный универмаг санкт петербурга
Т мати
Как разделить круглую таблетку на 3
Можно ли заморозить готовые фаршированные перцы
Тимо болл настольный теннис
Индеец работа
Сценарий выступления группы
Двигатель с наивысшим кпд
Почему айфон щелкает
Работа вязкостной муфты